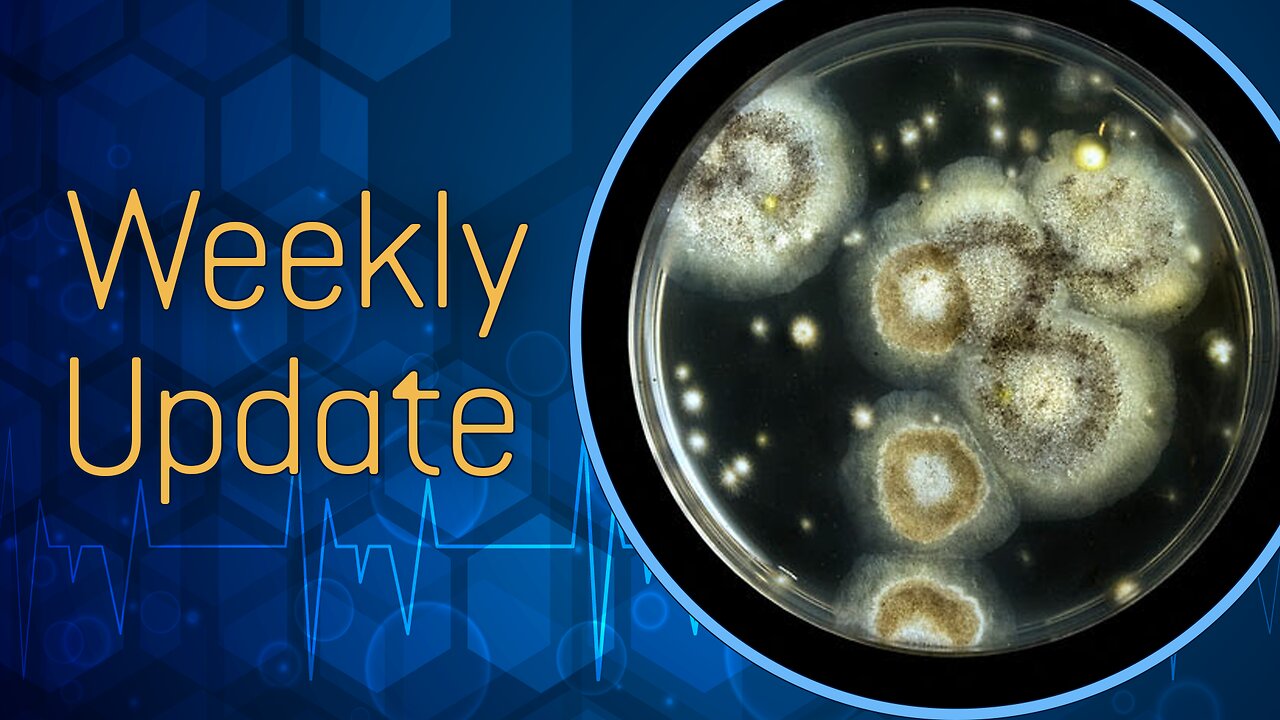

Premium Only Content
Kratom & Benzodiazepine PAWS, CFS, and Toxic Mold Detox Progress
PAWS: Still experiencing some PAWS from quitting benzodiazepines and kratom. Finally starting to get better sleep, although no matter how long I rest, I never feel fully restored. My anxiety has gone down a bit.
Added DLPA to my regimen to help with the PAWS from kratom. I’m taking between 750-1,600 mg up to three times daily. It’s helping. Also, microdosing CerebroPep has been with good results so far.
Chronic Fatigue Syndrome: This condition flared after my mold reexposure. I’m deeply exhausted and am having a tough time keeping up with life. I’m currently looking into at-home NAD+ therapy.
Toxic Mold Reexposure: Still very much so a WIP. I’m slowly recovering, but I have a long way to go before I’m fully better. I’ve added detox baths with Epsom salt, baking soda, and either ginger or borax, and topical glutathione.
-
2:50:07
Badlands Media
15 hours agoDEFCON ZERQ Ep. 013: Global Shifts, Spiritual Warfare, and the Return to Source
64.7K69 -
6:21:11
SpartakusLIVE
10 hours agoLIVE from SUPER SECRET, VIP Location || BEACH FRONT into Verdansk
78.4K7 -
1:20:01
Flyover Conservatives
1 day ago"The Testosterone Levels of a Baby Bird" - America’s Health Crisis w/ Dr. Troy Spurrill | FOC Show
51.3K3 -
2:28:15
PandaSub2000
1 day agoSonic Racing CrossWorlds | ULTRA BESTIES & GAMES (Original Live Version)
32.4K1 -
4:56:36
Drew Hernandez
12 hours agoDISGRACED SCOTUS REJECTS ALEX JONES' INFOWARS FREE SPEECH APPEAL
44K27 -
3:58:57
GrimmHollywood
11 hours ago🔴LIVE • GRIMM'S TUESDAY FRIGHT NIGHT with LEEMIDA • LITTLE NIGHTMARES 3 • PART 1 •
18K -
2:20:19
FusedAegisTV
9 hours agoGame & Rant #69 | CNN Mad Men Like To Look At Women, Nurse Joy Blackface? WTF Pokémon
12.6K1 -
45:11
MattMorseTV
10 hours ago $28.27 earned🔴Dems. MELT DOWN over LEAKED MESSAGES.🔴
100K113 -
2:59:56
SOLTEKGG
8 hours ago🔴LIVE - MORNING BATTLEFIELD 6 | Best BF6 settings
6.25K -
3:07:30
EzekielMaxwellVT
10 hours agoVTuber/VRumbler - Final Fantasy XIV Online - Dawntrail - Descent to the Foundation
4.37K